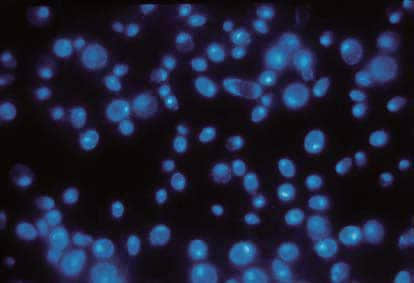
1653149042864980.jpg

细胞收集膜,全球领先的径迹蚀刻造孔技术
为了满足液基薄层法检测病变细胞的需求,如宫颈癌细胞筛查,提供全球领先的Whatman PET径迹蚀刻膜系列产品。该膜具有均一真实孔径,表面光滑,材质透明,直接捕获细胞或微生物,提供全系列孔径类型,用于透射荧光检测,信噪比极佳。
| 产品特征 | 优势及应用 |
| 生物惰性 | 适用于各种细胞检测 |
| 低蛋白吸附和低萃取溶出 | 膜本身不会对检测结构产生干扰 |
| 亲水和疏水表面可选 | 相较传统材料,背景信号低 |
| 不会被染色或标记 | 适应不同检测对透过和截留的需求 |
| 表面光滑平整 | 细胞或颗粒在膜表面易见并容易被反冲回收 |
| 低滞留体积低 | 样品回收率高 |
| 可控的光学特质(透明、半透明和染色的) | 保证检测的优质光学信噪比-透明的材料可以完全透过光线 |
|  |
| DAPI 染色观察黑色径迹蚀刻膜上的噬菌体细胞 | 电镜下径迹蚀刻膜表面上的乳胶颗粒 |
| 订货信息 |
货号 | 产品描述 | 包装规格 |
| 侧向流免疫NC膜 |
10548109 | AE98 F ast 25mm*50m | 1 卷/包 |
10549897 | AE99 18mm*50m, SIP | 1 卷/包 |
10548081 | AE99 25mm*50m | 1 卷/包 |
10540402 | AE99 25mm*100m BD | 1 卷/包 |
10549867 | AE100 25mm*50m | 1 卷/包 |
78336403 | Immunopore FP 25mm*50m | 1 卷/包 |
78356403 | Immunopore RP 25mm*50m | 1 卷/包 |
10547002 | FF80HP 20mm*50m | 1 卷/包 |
10547003 | FF80HP 25mm*50m | 1 卷/包 |
10547026 | FF80HP 39.5mm*50m | 1 卷/包 |
10547001 | FF120HP 25mm*50m | 1 卷/包 |
10547006 | FF120HP 20mm*50m | 1 卷/包 |
10547005 | FF170HP 25mm*50m | 1 卷/包 |
10549735 | Protran BA85 300mm*50m | 1 捐/包 |
10401003 | Protran BA85 300mm*3m | 1 卷/包 |
10549737 | PRIMA85 17mm*50m | 1 卷/包 |
| 细胞收集膜 |
113740 | PET膜 24cmx100m 7-8um | 1 卷/包 |
特殊定制的硝纤膜 |
78016711 | GM045 300mm*6m | 1卷/包 |
10549684 | FT020 150*150mm | 10张/包 |
10420001 | FT020 SHT 350mm*640mm | 10卷/包 |
10549713 | Prima 40 25mm*50m SIP | 1卷/包 |